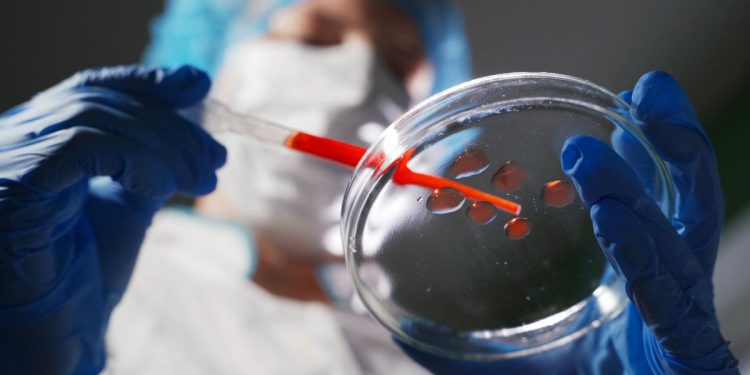
вирус

С начала 2025 года мир столкнулся с резким ростом числа заражений вирусом чикунгунья, передающимся через укусы комаров. Всемирная организация здравоохранения предупреждает: заразиться рискуют более 5,6 миллиарда человек в 119 странах. Об этом сообщает Reuters, передаёт RedMedia.kz.
«Он вызывает сильную лихорадку, боли в суставах и может привести к долгосрочной инвалидности», – заявила представитель ВОЗ Диана Рохас Альварес.
По её словам, вспышка началась в регионах, где вирус уже был активен в 2004–2005 годах. В частности, на островах Ла-Реюньон, Майотта и Маврикий. Только на Ла-Реюньоне вирусом заразилась треть населения. Быстрое распространение также фиксируется в Мадагаскаре, Сомали, Кении и странах Юго-Восточной Азии, включая Индию.
Угроза уже в Европе
ВОЗ выражает особую обеспокоенность ситуацией в Европе. С мая 2025 года во Франции выявлено около 800 завезённых случаев, а также 12 случаев локальной передачи – заразившиеся никуда не выезжали. Аналогичные случаи уже зафиксированы в Италии. Это означает, что вирус начал распространяться через местных комаров.
Чикунгунья передаётся преимущественно комарами рода Aedes, особенно Aedes aegypti и Aedes albopictus (тигровые комары), которые также являются переносчиками денге и вируса Зика. Эти насекомые наиболее активны в дневное время.
Нет лекарства, есть только профилактика
Специфического лечения от чикунгуньи не существует. Симптомы включают высокую температуру, мышечные и суставные боли, которые могут сохраняться месяцами. Основными средствами профилактики остаются использование репеллентов, ношение закрытой одежды и уничтожение мест размножения комаров.
«Если не принять срочных мер, мир может столкнуться с новой масштабной эпидемией, как в 2004–2005 годах», – предупреждает ВОЗ.
Организация призывает страны к активному мониторингу, информированию населения и усилению мер профилактики, особенно в зонах с тёплым и влажным климатом.
Ранее мы писали, что ВОЗ предложила поднять цены на табак, алкоголь и газировку на 50%